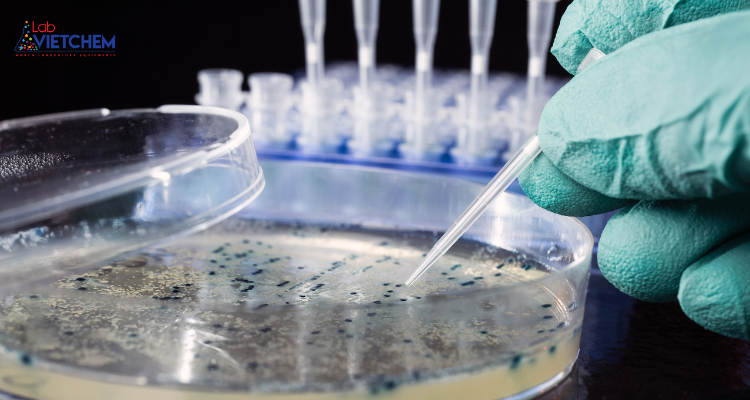
Môi trường nuôi cấy vi sinh vật
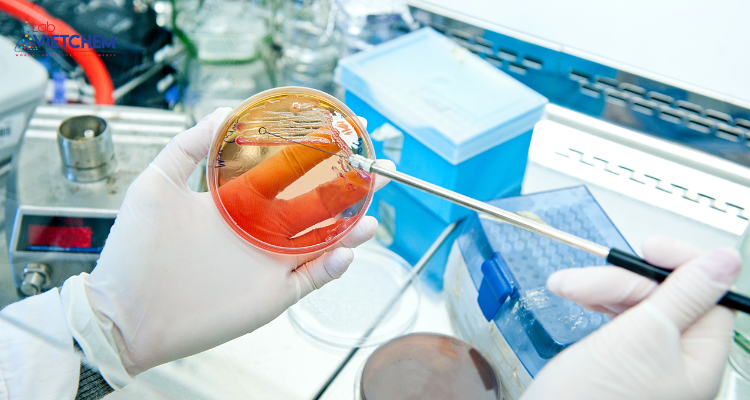
Kỹ thuật nuôi cấy vi sinh vật

Nội dung bài viết
Nuôi cấy vi sinh vật là một trong những phương pháp giúp chẩn đoán, xác định loại vi sinh vật để xác định nguyên nhân gây bệnh truyền nhiễm. Hiện nay có rất nhiều phương pháp nuôi cấy vi sinh vật phổ biến, chúng ta cùng tìm hiểu qua bài viết dưới đây nhé.
1. Phương pháp nuôi cấy vi sinh vật là gì?
Nuôi cấy vi sinh vật là phương pháp đặt mẫu bệnh phẩm nghi ngờ chứa vi sinh vật vào môi trường thích hợp để tạo điều kiện cho vi khuẩn phát triển. Môi trường nuôi cấy bên ngoài có bổ sung thêm chất dinh dưỡng hoặc các yếu tố đặc biệt để xác định đặc tính của vi sinh vật. Đây là phương pháp quan trọng để xác định chính xác loại vi khuẩn và nấm gây bệnh.
Trong quá trình nuôi cấy cần đảm bảo nguyên tắc vô trùng, tránh ô nhiễm tạp chất và các vi khuẩn khác từ bên ngoài.
Môi trường nuôi cấy vi sinh vật
2. Tóm tắt các phương pháp nuôi cấy vi sinh vật
Tùy theo mục đích nuôi cấy và loại mẫu vật mà chúng ta lựa chọn phương pháp nuôi cấy phù hợp.
Để đảm bảo quá trình nuôi cấy đạt hiệu quả, chúng ta cần chuẩn bị những hạng mục sau:
– Môi trường văn hóa phù hợp.
– Nước muối sinh lý 0,9%.
– Que cấy, pipet Pasteur.
– Tủ ấm, tủ an toàn sinh học.
– Ống nghiệm, đèn cồn,…
Dưới đây là một số phương pháp nuôi cấy vi sinh vật
2.1. Phương pháp ghép phân vùng
– Mục đích: Phương pháp này giúp phân lập vi khuẩn thành các khuẩn lạc riêng biệt. Từ đó, nguyên nhân gây bệnh có thể được xác định dễ dàng hơn.
– Mẫu vật: Dịch cơ thể, phân, mủ.
– Môi trường nuôi cấy chính: Thạch máu, thạch sôcôla, TCBS, Macconkey…
– Quá trình:
+ Chuẩn bị đầy đủ mẫu bệnh phẩm và môi trường nuôi cấy, ghi đầy đủ thông tin mẫu bệnh phẩm và ngày nuôi cấy lên đĩa thạch.
+ Que cấy cần được khử trùng trước khi lấy mẫu bằng cách đun nóng trên ngọn lửa hoặc khử trùng bằng cồn. Sau đó lấy mẫu và nuôi cấy, cách ly từng khu vực.
+ Cấy vùng 1: Bắt đầu nuôi cấy tại vùng gốc ở mép đĩa thạch trước. Sau đó di chuyển que nuôi cấy cùng mẫu vật dọc theo đường ngoằn ngoèo có diện tích chiếm ¼ diện tích đĩa thạch.
+ Cấy vùng 2: Tiếp theo chúng ta xoay đĩa 90 độ, cũng di chuyển implant theo đường zíc zắc nhưng thưa thớt hơn vùng 1. Cấy ¼ đĩa.
+ Cấy vùng 3: Xoay 90 độ rồi nuôi cấy như vùng 2 nhưng ít thường xuyên hơn và 2, 3 đường cấy ở vùng 3 phải chạm vùng 2 có diện tích nuôi cấy bằng ¼ đĩa thạch.
+ Khu cấy 4: Xoay đĩa 90 độ và nuôi cấy tương tự như trên với diện tích ¼ đĩa thạch cuối cùng.
+ Mỗi lần nuôi cấy ở một vùng khác nhau cần phải khử trùng vật liệu cấy ghép. Đối với những implant đã vô trùng một lần thì chúng ta cần thay thế một implant khác.
+ Sau quá trình nuôi cấy vi khuẩn, chúng tôi tiếp tục nuôi cấy trong tủ ấm ở nhiệt độ 37 độ C có hoặc không có khí Co2. Sau 18 – 24 giờ chúng tôi tiếp tục theo dõi sự phát triển của vi khuẩn.

Văn hóa phân vùng
– Lưu ý: Lưu ý các đường nuôi cấy ở khu vực phía sau phải tiếp xúc với các đường nuôi cấy ở khu vực trước để vi khuẩn có thể phát triển ở tất cả các khu vực hình thành các khuẩn lạc riêng biệt.
2.2. Phương pháp nuôi cấy đếm
– Mục đích: Xác định số lượng có thể phát triển trong 1 thể tích mẫu vật.
– Mẫu vật chính: Nước tiểu.
– Môi trường nuôi cấy: Thạch máu.
– Quy trình: Thực hiện với implant thể tích 1mcl.
+ Sau khi lấy đủ mẫu mô, dải nuôi cấy sẽ được ria thành một đường thẳng ở giữa đĩa thạch để tạo thành đường gốc.
+ Tiếp theo, ta rải đều vi khuẩn lên đĩa thạch theo đường zíc zắc và phải đi qua vạch gốc.
+ Cuối cùng, chúng tôi nuôi chúng trong máy tạo độ ẩm với nhiệt độ và thời gian thích hợp (khoảng 37 độ C trong 24 giờ).
Cứ sau 24 giờ, chúng tôi kiểm tra sự phát triển của vi khuẩn. Nếu thấy xuất hiện vi khuẩn gây bệnh thì tiến hành nhận dạng chúng bằng nhiều kỹ thuật khác nhau như nhận dạng dựa trên các đặc tính sinh hóa cơ bản, nhận dạng bằng API, máy tự động,… Sau khi tìm được chủng mầm bệnh, chúng ta tiến hành làm kháng sinh đồ,
Sau khoảng 48-72 giờ nuôi cấy, nếu không xuất hiện vi khuẩn thì mẫu bệnh phẩm không có vi khuẩn và cho kết quả âm tính.
3. Một số lưu ý trong quá trình nuôi cấy vi sinh vật
– Trong quá trình nuôi cấy phải đảm bảo vô trùng để tránh nhiễm các tác nhân, vi khuẩn có hại làm ảnh hưởng đến kết quả.
– Kỹ thuật và kinh nghiệm của người trồng cũng là yếu tố quyết định đến kết quả nuôi cấy vi sinh vật.
– Cần lấy mẫu đúng thời điểm và đúng kỹ thuật để có kết quả chính xác nhất.
Kỹ thuật nuôi cấy vi sinh vật
– Lựa chọn phương pháp nuôi cấy thích hợp cho từng loại vi sinh vật nghi ngờ.
Bài viết trên chia sẻ đến bạn đọc những thông tin về phương pháp nuôi cấy vi sinh vật và một số lưu ý trong quá trình nuôi cấy. Nếu có thắc mắc hãy để lại thông tin để đội ngũ chuyên nghiệp của chúng tôi giải đáp.

Nội dung được phát triển bởi đội ngũ truongchuvananhue.edu.vn với mục đích chia sẻ và tăng trải nghiệm khách hàng. Mọi ý kiến đóng góp xin vui lòng liên hệ tổng đài chăm sóc: 1900 0000 hoặc email: hotro@truongchuvananhue.edu.vn